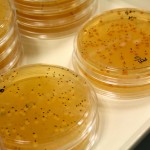
Mapa genético de la levadura del vino

Gracias a una investigación conjunta de la Universidad del País Vasco (EHU) y el centro tecnológico del mar y los alimentos Azti-Tecnalia, se han logrado determinar las características genéticas específicas que hacen única a la anchoa del Golfo de Bizkaia. Se trata de un gran paso que permitirá la diferenciación con respecto a otros ejemplares de anchoas de otras partes del mundo, la investigación genética podrá dar pie para la creación de un sello certificador de procedencia que garantizará al consumidor que está disfrutando de una auténtica anchoa del Golfo de Bizkaia. Incluso si la anchoa ha sido manipulada y envasada, se podrá verificar su verdadera procedencia.
El estudio todavía no ha concluido, pero se encuentra en la última fase, el nuevo método para diferenciar la anchoa del Golfo de Bizkaia se está validando y certificando su efectividad, se espera que a lo largo de este año ya esté acreditado. Para lograr desarrollar el «carné de identidad de la anchoa» los especialistas han tenido que analizar más de 3.000 ejemplares de diferentes segmentos de edad procedentes de diferentes aguas europeas, también se han estudiado ejemplares de otras cinco especies de anchoas de otros lugares del mundo.
Este proyecto nos recuerda el trabajo que ha permitido que el Instituto de Investigaciones Marinas de Vigo posea la mayor biblioteca genética de peces de nuestro país con un total de 300 especies secuenciadas genéticamente. Esta información es de gran valor y con ella se pueden detectar los fraudes, sobre todo en aquel pescado que se comercializa en porciones, medallones o filetes, alimentos que se identifican con etiquetas pero que no garantizan 100% la identificación de la especie o su procedencia.
Poco a poco se configura un archivo de mapas genéticos y variaciones genéticas de los alimentos marinos españoles que reducirá significativamente el fraude, recordemos por ejemplo que tras el descubrimiento del marcador genético del mejillón de Galicia, se ha emprendido un nuevo trabajo para descifrar el genoma del mejillón de Galicia. Este paso no sólo permite la diferenciación, también la comprensión de la especie con mayor profundidad y poder desarrollar nuevas variedades que sean más resistentes a las enfermedades, cambios de temperatura del agua, mejillones con mejores cualidades organolépticas, etc.
El proyecto para determinar los marcadores genéticos de la anchoa del Golfo de Bizkaia ha sido posible gracias a la financiación de los departamentos de Pesca y de Industria, Innovación, Comercio y Turismo del Gobierno Vasco y al Instituto Nacional de Investigaciones Agrarias, se trata de una inversión que otorgará un gran valor añadido a la comercialización de la especie. Volviendo al trabajo realizado por la EHU y Azti-Tecnalia, se ha recurrido a la genética por una razón evidente, no existen diferencias morfológicas claras entre la anchoa del Golfo de Bizkaia y la anchoa de otros lugares, esto es algo que propicia el fraude, si además el producto se presenta procesado, es imposible realizar una distinción, sin embargo, con los marcadores genéticos esto sí es posible.
La secuenciación y análisis del ADN permite la identificación genética de los alimentos, en este caso y a través de la noticia publicada en Deia, podemos saber que los investigadores han descubierto las variaciones en las secuencias de ADN producidas por los diferentes nucleótidos (moléculas o monómeros de los ácidos nucleicos presentes en genoma nuclear y mitocondrial), obteniendo un total de 16 variaciones distintas con las que poder realizar el test que mostrará el verdadero origen geográfico de la anchoa. Hay que decir que se están desarrollando otros estudios similares para diferenciar otros productos marinos como por ejemplo el bonito del norte, también se espera poder concluir la herramienta diferenciadora este año. En fin, hay que reconocer que se están realizando grandes esfuerzos para diferenciar los productos de calidad que nos ofrecen las comunidades autónomas españolas de Galicia, Cantabria, Asturias o el País Vasco.

2 comentarios
Todas estas iniciativas con el fín de lograr una trazabilidad REAL y SEGURA del producto son siempre bienvenidas, a ver si de una vez por todas terminamos con la picaresca en este y otros muchos manjares …
¿Pero qué pasa con los movimientos migratorios de las especies? ¿El ADN obtenido qué seguridad otorga de que la anchoa no venga de otro lugar pero por migración? ¿Me quieren decir que la especie se originó en el Golfo de Vizcaya? No se arroguen tanto mérito, que todo no ha salido de allí. Recuerden que además el método de la salazón lo implantaron los italianos en Cantabria y País Vasco simultáneamente.